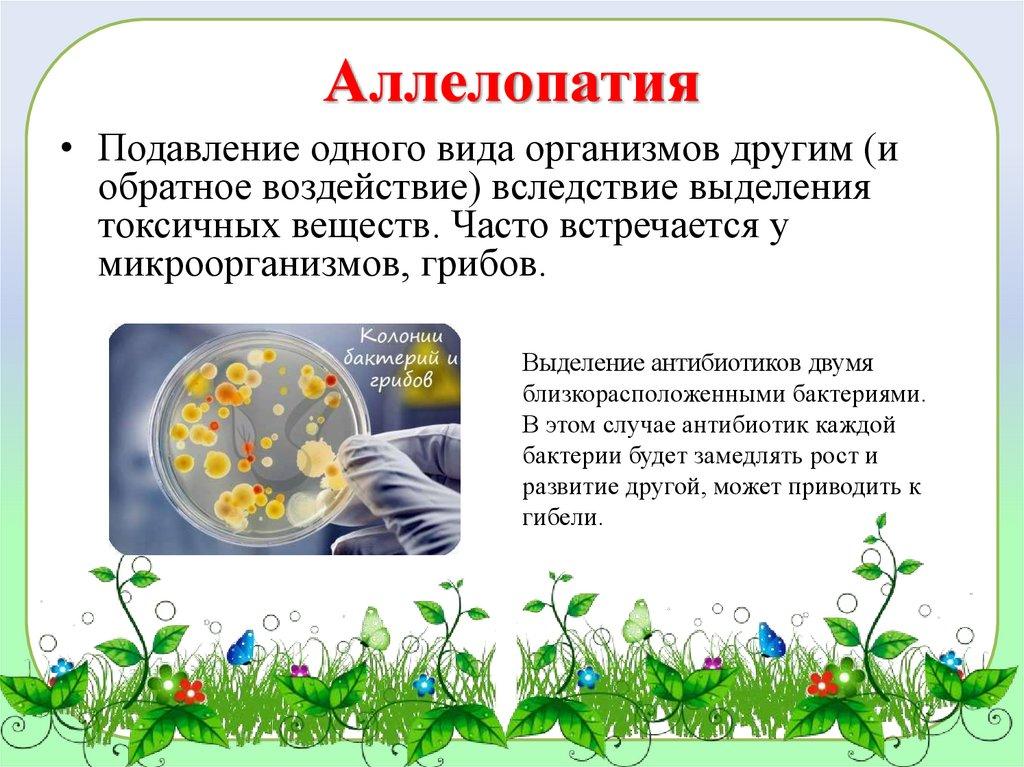

Похожие презентации:
Биотические взаимодействия. Прямые биотические факторы
1.
Биотические взаимодействия2.
Биотические взаимодействия (факторы) —это все формы взаимоотношений в среде их обитания.
Прямые биотические факторы характеризуются
личным воздействием одних организмов на другие.
Косвенные факторы воздействуют на жизнь других
видов опосредованно. Например, растения, изменяя
своим присутствием освещение и влажность, влияют
на жизнедеятельность животных или других растений.
3.
Биотические отношенияНейтрализм 00
Взаимнополезные ++
протокооперация
мутуализм
Полезнонейтральные +0
комменсализм
Полезновредные
паразитизм
+-
симбиоз
хищничество
Взаимновредные - -
конкуренция
Вреднонейтральные – 0
аменсализм
антибиоз
4.
Нейтрализм – формавзаимоотношений, при
которой совместно
обитающие на одной
территории организмы
не влияют друг на друга,
но зависят от состояния
сообщества в целом.
Пример: белка и лось.
5.
Мутуализм – взаимовыгодное сожительство организмов,построенное на пищевых связях
В рамках мутуализма можно выделить кооперацию и
симбиоз
Рыба-клоун спасается от врагов
среди щупалец актинии, проводит
там санитарную обработку: она
удаляет из актинии не переваренные
остатки пищи, вентилирует воду.
6.
Кооперация – необязательное взаимовыгодноесожительство, построенное на пищевых связях между
организмами двух или более видов.
Актиния крепится к панцирю ракаотшельника, своими щупальцами
обездвиживает мелких животных,
таким образом, достает пищу для
себя и рака. Рак-отшельник
постоянно перемещает актинию, за
счет чего вероятность ее встречи с
потенциальной жертвой
увеличивается.
7.
Симбиоз – это форма совместноговзаимовыгодного существования организмов
разных видов, построенная, как правило, на
пищевых отношениях.
Симбиоз может быть облигатным
(обязательным) и факультативным (не
обязательным).
8.
Облигатный симбиозОрганизмы не могут существовать друг без друга.
Лишайники,
организмы,
образованные
симбиозом гриба и
водоросли.
9.
Комменсализм - форма сожительства особей разных видов,при которой один из членов системы (комменсал) живет за
счет другого (хозяина), не причиняя последнему вреда.
При этом для видов-хозяев присутствие комменсалов
безразлично.
10.
Существуют различные формы комменсализма:Пищевые
«Жилищные"
Нахлебничество
Квартирантство
Сотрапезничество
11.
Нахлебничество - это потребление остатков пищихозяина.
«Нахлебничество» рыба-прилипала
(комменсал) прикрепляется к акуле,
преодолевает большие расстояния и
питается
остатками
пищи,
расплывающимися в стороны после
трапезы акулы.
12.
Сотрапезничество - форма комменсализма, при которойнесколько видов потребляют разные вещества или части
одного и того же ресурса.
Различные виды
почвенных бактерий
перерабатывают
отдельные компоненты
почвы
13.
Квартиранство - это использование одними видами других(их тел или их жилищ) в качестве убежища (жилища) или
транспортного средства (как "извозчиков").
«Квартиранство", при котором один
из организмов использует другой как
жилище: в мантийную полость
двустворчатых
моллюсков
откладывают
икринки
рыбыгорчаки,
благодаря
чему
развивающиеся икринки надежно
защищены раковиной моллюска, но
не приносят ни вреда, ни пользы
самому моллюску.
14.
Аменсализм - это такие биотические отношения, прикоторых для одного из двух взаимодействующих видов
последствия совместного обитания отрицательны
(угнетение роста, размножения и др.), а для другого безразличны.
Высокие
широкие
кроны
взрослых деревьев, которые
практически не пропускают
свет в подлесок и тем самым
угнетают
рост
молодых
растений, мхов.
15.
Конкуренция - взаимоотношения между организмамиодного или разных видов, которые выражаются в
соперничестве организмов за право обладания одинаковыми
ресурсами среды.
Конкуренция - соревнование между особями за средства
существования и условиями размножения.
16.
КонкуренцияВнутривидовая
Межвидовая
17.
Хищничество - такой типотношений, при котором
особи одного вида
(хищники) поедают особей
другого вида (жертву). В
основе отношений "хищникжертва" лежат пищевые
связи.
18.
Виды хищничества19.
Хищничество у животныхМедведь ловит семгу
Гепард и косуля
Божья коровка и тля
20.
Хищные растенияВенерина мухоловка
Росянка
Непентес
21.
Паразитизм - форма отношений между организмами,при которых один (паразит) использует другого (хозяина)
в качестве среды обитания и источника питания.
22.
Формы паразитизма1. Облигатный (обязательный) - паразит не может существовать вне
организма хозяина (ленточные черви).
2. Факультативный (необязательный) - паразит поселяется в организме
хозяина, приводит его к гибели и продолжает свое существование в
мертвом теле (некоторые нематоды)
3. Временный – контакт с организмом хозяина происходит в отдельных
стадиях жизненного цикла паразита или в определенный промежуток
времени (кровососущие насекомые)
4. Постоянный (стационарный) – взаимодействие паразита и организма
хозяина происходит постоянно (вирусы)
Различают эндопаразитов – живут в теле своего хозяина и питаются его
тканями и содержимым пищеварительного тракта ( печеночный
сосальщик, малярийный плазмодий) – внутренний паразитизм и
эктопаразитов - живут преимущественно на коже организмов-хозяев и
обладают достаточной подвижностью, чтобы переходить от одного
хозяина к другому (блохи, вши) – наружный паразитизм.
23.
Гнездовой паразитизм24.
Аллелопатия• Подавление одного вида организмов другим (и
обратное воздействие) вследствие выделения
токсичных веществ. Часто встречается у
микроорганизмов, грибов.
Выделение антибиотиков двумя
близкорасположенными бактериями.
В этом случае антибиотик каждой
бактерии будет замедлять рост и
развитие другой, может приводить к
гибели.
25.
Все перечисленные формы биологических связеймежду видами служат регуляторами численности
животных и растений в биоценозе, определяя
степень его устойчивости; при этом чем богаче
видовой состав биоценоза, тем устойчивее
сообщество в целом.

Биология
Биология








